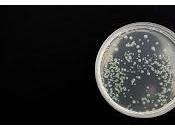
infección Bartonella asocia trastornos psiquiátricos

Revista Salud y Bienestar
ÚLTIMOS ARTÍCULOS DE LOS PAPERBLOGUEROS
-
Relación del microbioma intestinal con la obesidad y la diabetes tipo 2

IntroducciónSe podría decir que el microbioma intestinal (MI) en los seres humanos es un órgano con funciones críticas para el metabolismo, la digestión, el... Leer el resto
El 20 diciembre 2020 por Byrock66
-
Factores socieconómicos y desnutrición o el riesgo de desnutrición en los...
La desnutrición en las personas mayores se podría enfrentar abordando los factores socioeconómicos. Este estudio tuvo como objetivo determinar la magnitud de... Leer el resto
El 24 diciembre 2020 por Edogallegos
-
Epidemiología global del hipertiroidismo e hipotiroidismo

IntroducciónLas hormonas tiroideas actúan en casi todas las células nucleadas y son esenciales para el crecimiento normal y el metabolismo energético. La... Leer el resto
El 20 diciembre 2020 por Byrock66
-
La infección por Bartonella se asocia a trastornos psiquiátricos
Un estudio realizado por investigadores de la Universidad Estatal de Carolina del Norte ha encontrado casos de infección por Bartonella en humanos que... Leer el resto
El 08 diciembre 2020 por Jesus Gutierrez
-
Cuál es la mejor báscula profesional

Todo Dietista-Nutricionista necesita una báscula profesional. En ete artículo vamos a ver cual es la mejor de las básculas profesionales y por qué... Leer el resto
El 04 diciembre 2020 por Yago Perez
-
Cómo solicitar la devolución de ingresos indebidos a la Seguridad Social
Se dan ocasiones en las que, por error, se reciben ingresos que no nos corresponden. Tanto si ha habido un error de ingresos de más como de menos. Las... Leer el resto
El 11 diciembre 2020 por Pedirayudas
-
Nuxe: el remedio natural antiedad.

Cosmética natural para las diferentes fases por las que pasa tu piel, de la mano de Nuxe. Ya sé lo que estas pensando. Yo no tengo arrugas. No se ven aún, amiga... Leer el resto
El 09 diciembre 2020 por Palomapayno
-
Todo lo que hay que conocer y lo que falta sobre el Orgasmo Femenino

1. Cuando las mujeres tienen un orgasmo, ¿qué sucede realmente?Los músculos del suelo pélvico se contraen rítmica e involuntariamente ayudando a... Leer el resto
El 02 diciembre 2020 por Jesus Gutierrez
-
Terapia ocupacional

: La actividad como herramienta terapéutica.La actividad es una condición fundamental en la vida del hombre, todos tenemos una tendencia innata y espontánea a... Leer el resto
El 29 diciembre 2020 por Salud Abuelos Maria Perez
-
Blog ganador primer premio UBA a divulgación de contenidos educativos

Hola a todxs como están? espero que todo bien a pesar de haber sido una año tan especial y tan relacionado con la educación virtual, con la que me relaciono hac... Leer el resto
El 15 diciembre 2020 por Gabriela Marisa Iglesias
IR MÁS ALLÁ
-
10 consejos para limpiar y cuidar tu calzado
El 04 diciembre 2020 por Plantillascoimbra :
-
2020 un ano para APRENDER
El 31 diciembre 2020 por Enferevidente :
-
El SEPE avisa que efectuara mantenimiento en su Sede Electrónica
El 28 diciembre 2020 por Pedirayudas :
-
Actuar hoy para prevenir el cáncer profesional de mañana
El 01 diciembre 2020 por Alimentatubienestar :
-
¿Usas Twitter para informarte? Pues las noticias falsas son las que más se retuitean
El 15 diciembre 2020 por David Ormeño : Tecnología
-
La ONU denuncia crímenes contra la humanidad "sin igual", en Corea del Norte.
El 20 diciembre 2020 por Ximoas Jas : Deportes,
-
¿Debemos olvidar a ETA? ¿Y a HB?
El 01 diciembre 2020 por Ximoas Jas : Deportes,
-
La Seguridad Social y el derecho a la asistencia sanitaria
El 05 diciembre 2020 por Pedirayudas :
-
Los nervios nociceptivos regulan la movilización de las células madre
El 24 diciembre 2020 por Jesus Gutierrez :
-
Lignaform gama roja una forma fácil de cuidarte sin pasar hambre
El 25 diciembre 2020 por Farmaciamarket :
-
Sainete inocente
El 28 diciembre 2020 por Enferevidente :
-
Pulpo a la gallega
El 03 diciembre 2020 por Yago Perez :
-
Tratamiento de la Anemia Falciformes con Edición Genética
El 05 diciembre 2020 por Jesus Gutierrez :
-
Disfruta del sexo de una forma diferente
El 20 diciembre 2020 por Farmaciamarket :
-
¿Por qué han llegado tan rápido las vacunas contra la covid-19?
El 28 diciembre 2020 por David Ormeño : Tecnología
-
Shunga una marca para disfrutar en pareja
El 18 diciembre 2020 por Farmaciamarket :
-
Combatiendo el coronavirus, Vitamina B, imprescindible
El 26 diciembre 2020 por Farmaciamarket :
-
¿Se cobra paga extra de navidad del Ingreso Mínimo Vital? NO, porque no tiene pagas extra
El 03 diciembre 2020 por Pedirayudas :
-
Cómo reclamar ante la Seguridad Social a través de presentación de otros escritos y comunicaciones
El 22 diciembre 2020 por Pedirayudas :
-
Cambios en el cristalino por la edad.
El 02 diciembre 2020 por Beatrizmayoral :
 DÍA MUNDIAL DE LA SALUD
DÍA MUNDIAL DE LA SALUD
 PÍLDORA ANTICONCEPTIVA
PÍLDORA ANTICONCEPTIVA
 DÍA MUNDIAL DEL AUTISMO
DÍA MUNDIAL DEL AUTISMO
 VIH
VIH
 VPH
VPH
 MANUEL ALEXANDRE
MANUEL ALEXANDRE
